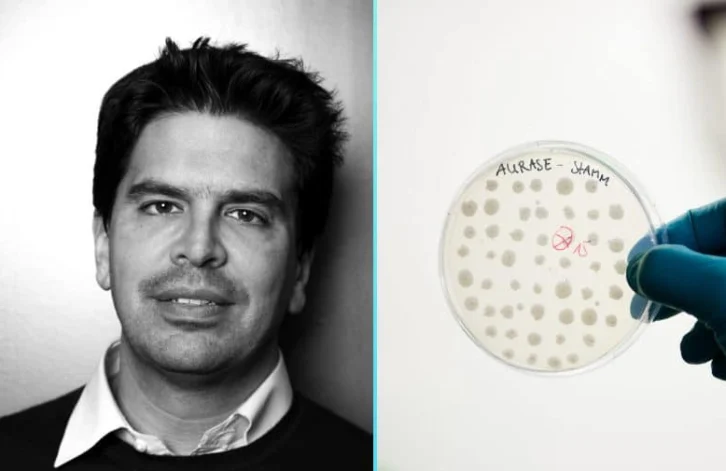

It is estimated that the UK spends over £3 billion on treating chronic wounds each year. In addition to this, there is a significant escalation in the cost, the considerable distress to patients and families if the only course of treatment for non-healing wounds is amputation. This calls for real innovation in this sector.
One such innovative solution has been developed by a Cambridge-based biotech startup SolasCure. It develops proprietary technology leveraging biomimicry and evidence-based medicine to empower health care professionals to treat patients with chronic wounds.
Focuses on wound cleaning product Aurase
Now, SolasCure announced the completion of its Series A investment round of £15 million. The raise began with the investment from BRAIN Biotech AG, SolasCure’s largest shareholder. Also, it was completed following investment by Seneca Partners, an investment management business based in the UK.
Other notable investors in SolasCure include Bionova Capital, experienced entrepreneur and life sciences angel investor Jonathan Milner (founder of Abcam), strategic investor EVA Pharma, the Development Bank of Wales, as well as François Fournier (former lead of Smith & Nephew’s Advanced Wound Care division).
The investment will be used to support the development of their wound cleaning product, Aurase. It is a hydrogel containing an enzyme cloned from medical maggots that can be used to support healthcare professionals treating patients with chronic wounds.
Speaking upon the completion of the round, Dr Sam Bakri, Founder and CEO of SolasCure said: “We are delighted to have completed our Series A round, which will help us to move onto the clinical trial stages of product development. We are excited to be working with such knowledgeable and specialist investors, as they join us on our mission to support healthcare professionals with wound care products that significantly improve the health and wellbeing of patients with chronic wounds.”
Adriaan Moelker, CEO BRAIN Biotech AG, said: “It has been an encouraging sign for all partners that SolasCure has been able to successfully close another financing round with rising pre-money valuation during the pandemic. We continue to be committed to support SolasCure on its way to market for the innovative wound debridement enzyme Aurase®.”
Speaking on their investment, Matt Currie, Investment Director at Seneca said: “We are delighted to support SolasCure as part of this latest funding round. The team they have brought together are truly world-class, producing ground-breaking work in the wound care sector. Practitioners are crying out for a high-quality solution that can be transported, stored, and administered in an efficient and effective way, something severely lacking in the treatments available at present. We believe SolasCure’s Aurase product has the potential to become the go-to solution in this space”.